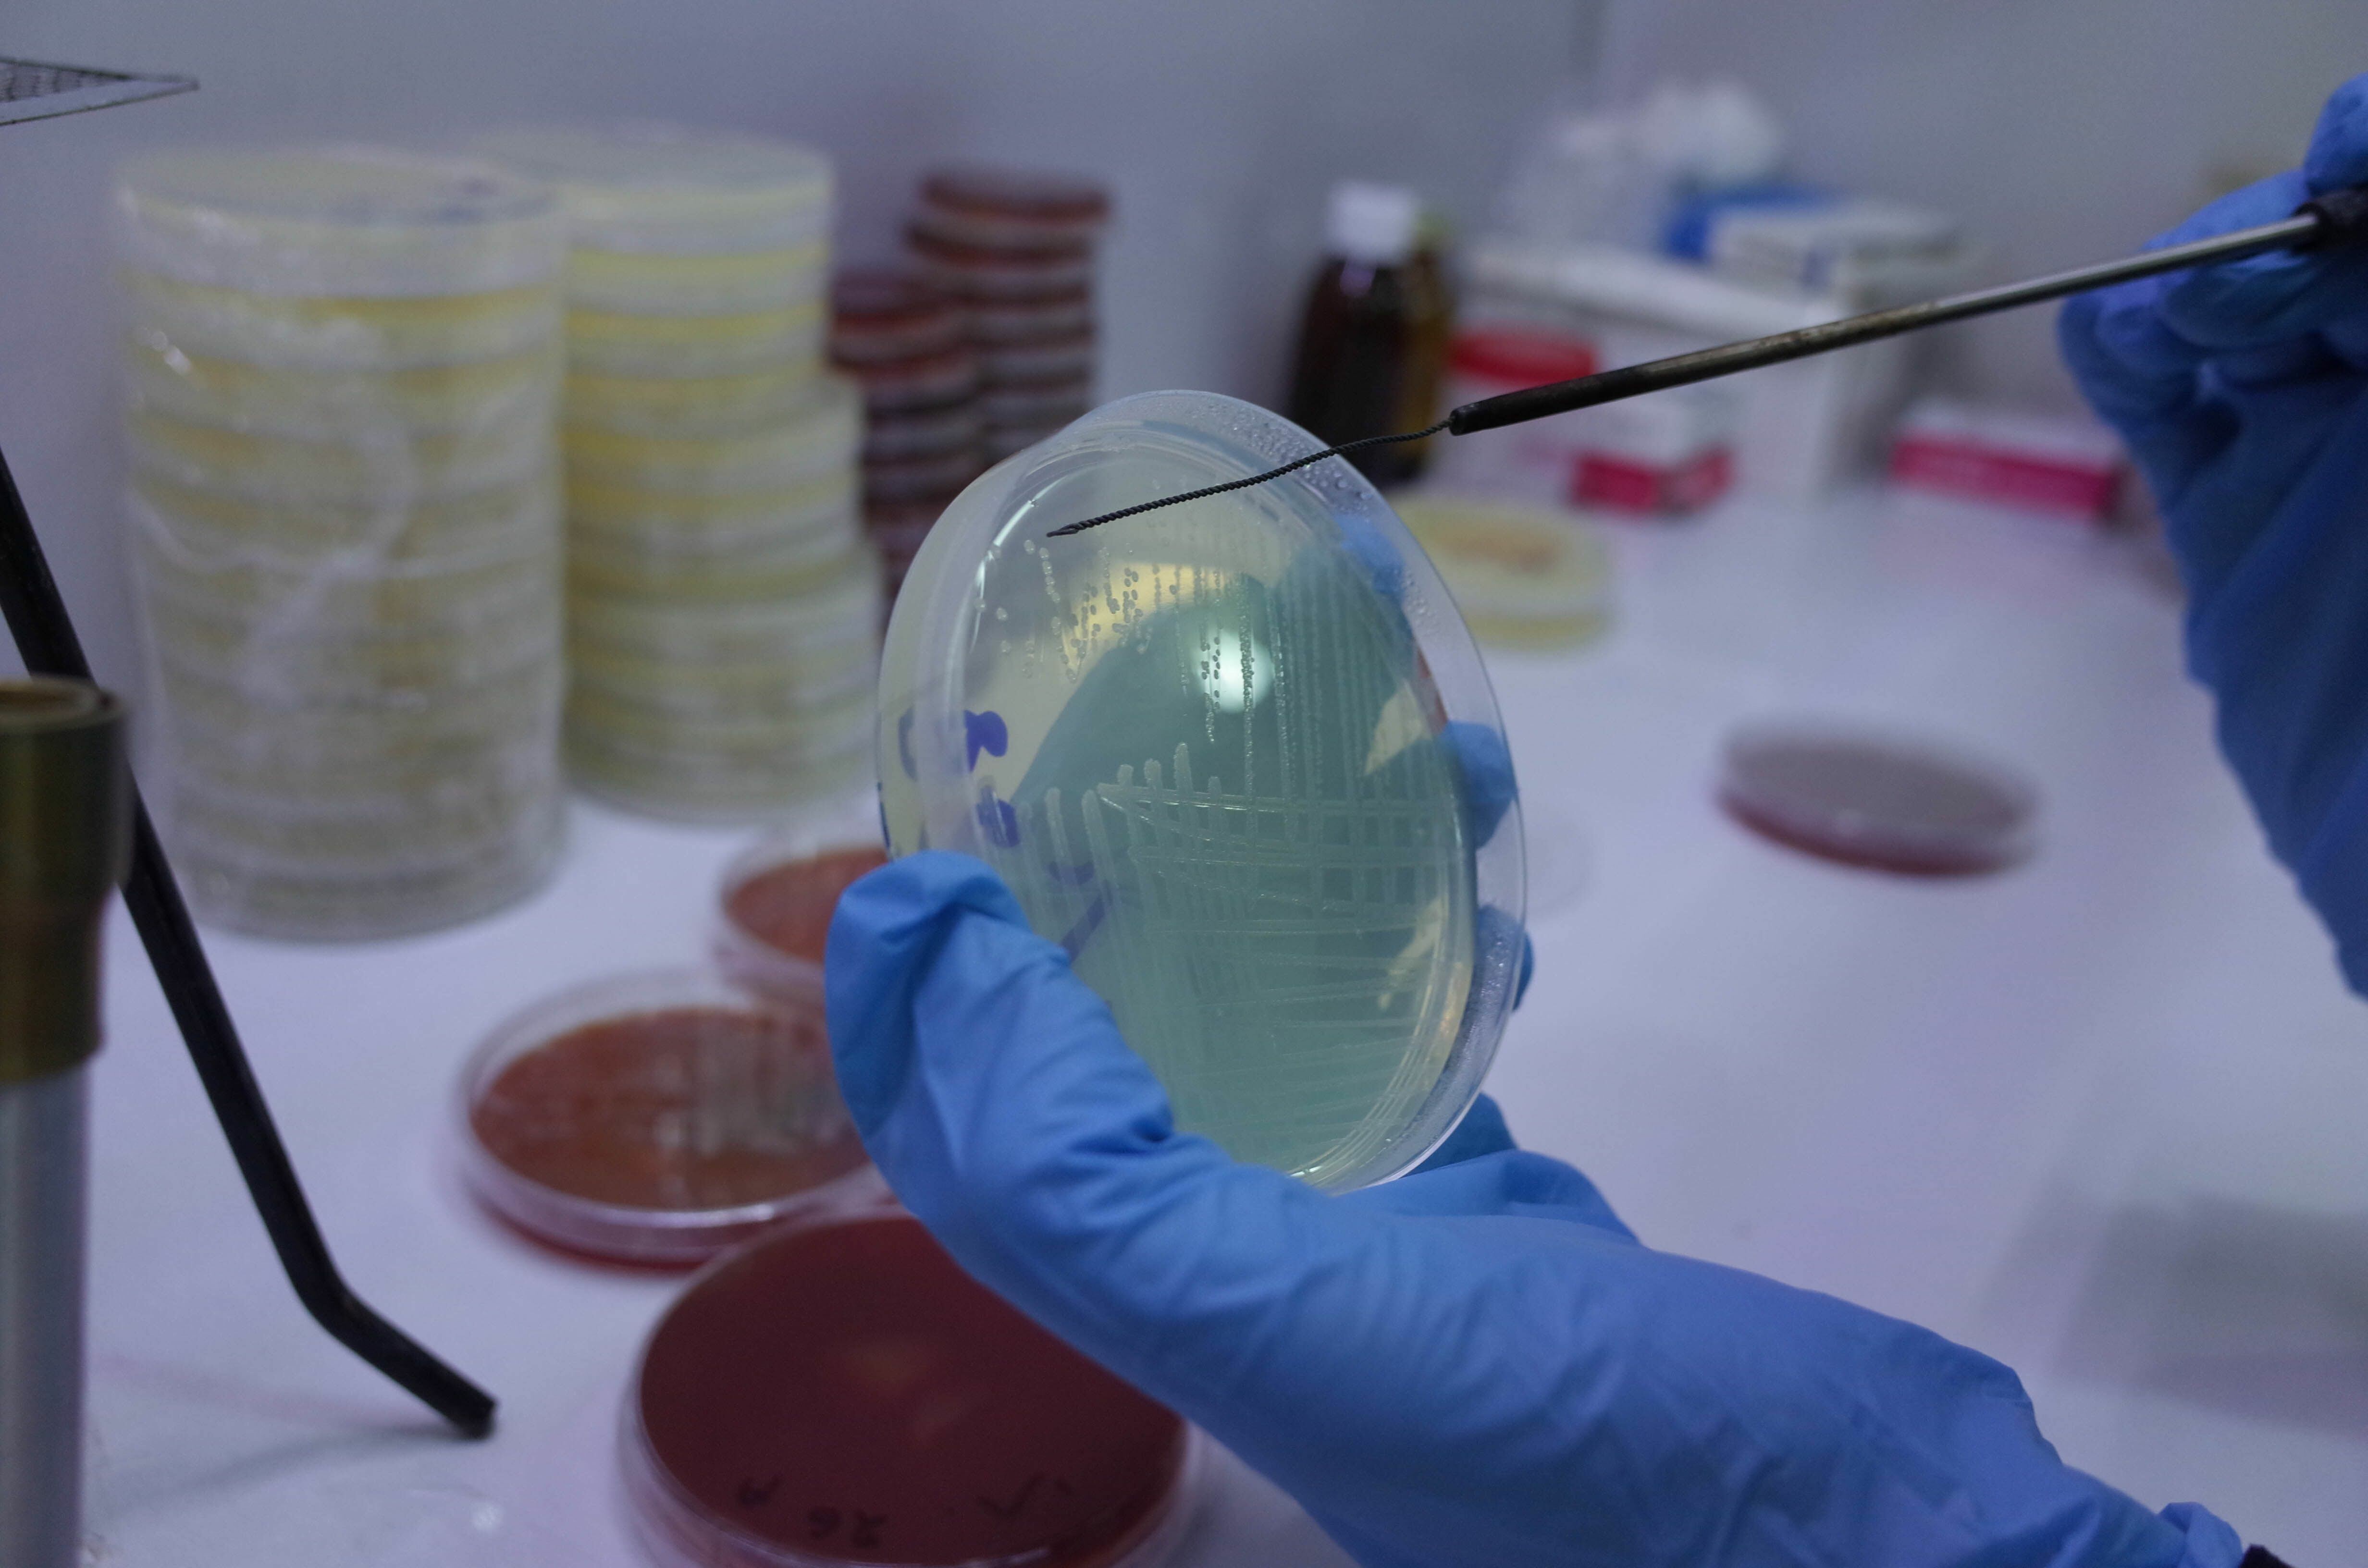
Las bacterias de los hemocultivos son idénticas a las encontradas en las ampollas del fentanilo contaminado (AdobeStock)

El Cuerpo Médico Forense relacionó la muerte de otros doce pacientes con el fentanilo contaminado de la empresa HLB Pharma Group SA, propiedad de Ariel García Furfaro. El resultado surge del segundo informe presentado por los peritos oficiales ante el juzgado federal de La Plata a cargo de Ernesto Kreplak. Los especialistas determinaron “nexo concausal” entre el cuadro infeccioso contraído en unidades de cuidados intensivos de hospitales y clínicas donde eran tratados y la administración del lote 31.202 de medicamento contaminado con las bacterias Ralstonia mannitolilytica y Klebsiella pneumoniae, aisladas tanto en los hemocultivos de los pacientes como en las ampollas de la misma partida de fentanilo.
El informe indica que de las otras veinte historias clínicas peritadas (el primer informe había estudiado una cantidad similar) el fallecimiento se debió a un “nexo concausal”, para las víctimas analizadas. Esto es que el cuadro infeccioso está vinculado a los bacilos Gram negativos multirresistentes (BGN-MR) “con demostrada identidad fenotípica, molecular y genómica con los recuperados de las ampollas de Fentanilo de HLB Pharma. Para los profesionales significa que el medicamento contaminado fue “un factor relevante que agravó la condición de personas ya afectadas por cuadros clínicos complejos (por ejemplo, múltiples comorbilidades, estado crítico previo) y que contribuyó en forma significativa a que el desenlace sea fatal”.
En uno de los puntos más salientes, los peritos, que dependen de la Corte Suprema de Justicia, presentaron un estudio científico que demostró que las bacterias gram negativas con las que estaban infectadas las ampollas de fentanilo de HLB Pharma aumentó en un 52% la mortalidad de los pacientes dentro de los 30 días.
Si bien se trata de un tema complejo, y muy técnico, Infobae trascribe de manera textual lo expuesto por los peritos de la Corte ya que podrían ser utilizado como uno de los argumentos del magistrado al momento de enumerar las pruebas contra los acusados al dictar los procesamientos, si es que así lo decide.
Los párrafos centrales de volcados en el informe dicen:
- “Ralstonia: Es un bacilo Gram negativo no fermentador oportunista que posee gran habilidad de supervivencia en condiciones de bajos nutrientes con posibilidad de sobrevivir en soluciones. No es un microorganismo habitualmente asociado a infecciones intrahospitalarias por lo que su presencia en hemocultivos obliga a pensar en la posibilidad de contaminación de infusiones, soluciones, sueros o medicamentos administrados”.
- “Klebsiella: es un bacilo Gram negativo, caracterizado por su elevada virulencia y capacidad infectante. A diferencia del microorganismo previamente mencionado se trata de un agente de elevada frecuencia de presentación como agente causal de infecciones asociadas al cuidado de la salud, especialmente en unidades cerradas de nuestro medio”.

- “El Estudio Epidemiológico Multicéntrico realizado en Argentina en el período comprendido entre julio de 2020 y marzo 2022, denominado EMBARCAR, evidenció esta problemática. Dicho estudio, que abarcó 34 centros e incluyó a 466 pacientes con bacteriemias intrahospitalarias, el 75% de los pacientes se encontraban internados en Unidad de Cuidados Intensivos, identificó a Klebsiella como el microorganismo implicado en el 53 % de los casos, observándose además que el 50% presentaba un perfil de resistencia tipo MBL (metalo-beta-lactamasas). La mortalidad global asociada por estas bacteriemias fue del 52% con una mortalidad dentro de los 30 días asociada a bacteremias a Klebsiella del 49%”.
- “El estudio EUROBACT-2 que analizó infecciones del torrente sanguíneo adquirida durante la asistencia de pacientes asistidos en unidades de cuidados intensivos, reportó una mortalidad del 37% a los 28 días”.
- “Es frecuente que, las bacterias productoras de MBL posean además otros mecanismos de resistencia asociados hacia otras familias de antimicrobianos confiriéndole perfiles de multirresistencia antibiótica lo cual limita las opciones terapéuticas. La multirresistencia antimicrobiana es un factor crítico que ha demostrado incrementar la mortalidad”.

En el informe los peritos informan no se pudo determinar la muerte de pacientes por “nexo causal directo”. Esto es cuando la infección producida por las bacterias halladas en el fentanilo contaminado constituye la causa exclusiva y principal de la muerte, sin coexistencia de otra condición clínica grave ni comorbilidad que explique por sí sola el desenlace fatal. Un hecho que parece ser obvio ya que los pacientes cursaban cuadros clínicos complejos, con múltiples comorbilidades y estados críticos previos.
Los mismo especialistas del Cuerpo Médico Forense reconocieron que la administración del fentanilo contaminado agravó la situación clínica de los enfermos ya que la infección por los microorganismos agravó de manera significativa la condición clínica, pero no fue la única causa de muerte.
De esta manera, el número de pacientes fallecidos por “nexo concausal” asciende a veinticuatro. Hasta ahora se peritaron 40 de las 122 historias clínicas incorporadas al expediente de pacientes fallecidos presuntamente vinculados al lote del fentanilo mortal. Pero la lista de veinticuatro pacientes fallecidos por “nexo concausal” puede aumentar ya que el magistrado solicitó que se analicen algunas historias clínicas de pacientes que fueron descartados por inconsistencias o errores en el momento en que se confeccionaron alguna de las precarias historias clínicas, como, por ejemplo, la fecha de ingreso del paciente al hospital o clínica y cuando se les administró el fentanilo.
En la causa hay 17 imputados, siete de ellos están detenidos. Entre ellos destacan Ariel García Furfaro y sus dos hermanos, Diego y Damián. Su madre, Nélida Furfaro también imputada, quedó en libertad por problemas de salud y porque tiene que cuidar a su propia progenitora de 88 años, Olga Furfaro, quien figura como presidenta de HLB Pharma.

Desde hoy, Kreplak tiene diez días hábiles para resolver la situación de cada uno de los imputados ya que ayer declaró el último sospechoso.
El segundo informe pericial del Cuerpo Médico Forense al que este medio accedió de manera exclusiva concluye, como el primero, en que la fuente de infección y la causa agravante de la mortalidad en los pacientes estuvo vinculada al uso de fentanilo contaminado con bacterias gram negativas multirresistentes, en especial Ralstonia mannitolilytica y Klebsiella pneumoniae, con concordancia plena entre los aislamientos bacterianos de las ampollas y los hemocultivo que aumentaron notablemente el riesgo de muerte y complican la respuesta clínica debido a su resistencia antibiótica y su capacidad de generar brotes en entornos hospitalarios.




